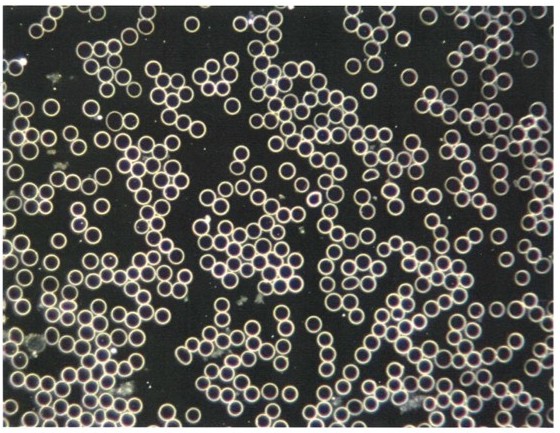

Am Montag den 05.10.2020 hat sich die Familie Kalbermatten für ein Experiment zur Verfügung gestellt. Dabei sollte untersucht werden, ob das Autofahren in einem Elektroauto, somit das Sitzen in einem durchtränkten Elektrosmogbereich, sich auf das Blutbild der Testpersonen auswirkt. Dabei sind erstaunliche Blutbilder anhand eines Dunkelfeldmikroskop entstanden. Das Experiment sollte in drei Schritten absolviert werden:
- Blutbild nach Erholungsphase (Schlaf) ohne vorgängigen Einfluss durch Elektrosmog
- Blutbild nach 30 Minuten im Elektroauto
- Blutbild nach 30 Minuten im Elektroauto mit Neutralisationstechnologie
Leider konnte die Familie den ersten Schritt nicht vollziehen, da die Anreise zum Untersuchungsort bereits mit dem Elektroauto stattgefunden hat. Ein optimales Blutbild unter dem Dunkelfeldmikroskop sollte wie folgt aussehen:
Folgende Personen wurden zum Test beigezogen:

Folgende Eckdaten zu den Testpersonen:

Pascale Angelika Kalbermatten
Alter: unbekannt
Grösse: 1.63m
Gewicht: sehr leicht

Youri Andrin Kalbermatten
Alter: 8 Jahre
Grösse: 1.30m
Gewicht: 28 kg

Thomas Kalbermatten
Alter: 37 Jahre
Grösse: 1.73m
Gewicht: 83kg
Nach dem Schritt 2, also ca. 30 Minuten Elektroautofahrt konnte man folgende Blutbilder pro Testperson festmachen:
Thomas Kalbermatten
Youri Andrin Kalbermatten
Pascale Kalbermatten
S2



Analyse Blutbild nach Schritt 2:
Bei dem ersten Blutbild von Thomas Kalbermatten erkennt man sehr gut, wie die Blutkörper sich bereits anziehen. Dabei muss vorausgesagt werden, dass die Blutkörper für ihre volle Funktionsfähigkeit, naturgemäss sich abstossen sollten. Man spricht von dem Münzenrolleneffekt und deutet darauf hin, dass die roten Blutkörper keine Nährstoffe sowie Sauerstoff mehr transportieren können. Das Blut ist verklummt, welches nicht gerne durch ihre Leitungen fliesst. Es stellt sich rasch einen höherer Blutdruck ein. Bei Youri erkennt man bereits, das sich die Blutkörper etwas näher kommen. Das Blutbild von Pascale sieht sehr gut aus.
Thomas Kalbermatten
Youri Andrin Kalbermatten
Pascale Kalbermatten
S3



Analyse Blutbild nach Schritt 3:
Nachdem die Memon-Technologie eingebaut wurde und alle Testpersonen weitere 30 Minuten unterwegs waren, hat sich das Blutbild tatsächlich in kürzester Zeit wieder verändert. Bei Thomas und Youri erkennt man eine massgebende Verbesserung des Blutbildes. Ebenso erkennt man Schwermetalle im Blut von Thomas (oranger Punkt). Auch das Blutbild von Pascale hat sich etwas verbessert, jedoch muss man bei der Gegenüberstellung feststellen, dass Pascale mit Abstand am wenigsten Veränderungen aufweist.
Die Bilder sprechen für sich. Als vierten Schritt wird Thomas nach 3 Wochen Elektroauto fahren mit der Neutralisationstechnologie nochmals ein Bild machen lassen. So kann auch eine Langzeitwirkung beurteilt werden. Leider stellt sich nun die Frage, wie das Blutbild Schritt 1 ausgesehen hätte. Ebenso stellt sich die Frage, wieso Pascale fast schon immun gegenüber Elektrosmog erscheint. Diese Fragen können nicht abschliessend beantwortet werden. Auf jeden Fall ist das Experiment hinsichtlich der Notwendigkeit, gegenüber Elektrosmog etwas sensibler eingestellt zu sein, sicherlich ein Erfolg. Auch das die Technologie einen positiven Effekt, zumindest auf die Funktionalität bzw. Polarisierung der Blutkörper aufweist.
Update folgt!

Wieso mein Blutbild so aussieht kann man gut erklären.
Seit Jahren setzte ich mich intensiver mit der geistigen Welt, Quantenheilung und Schwingungsmedizin auseinander und durfte einige Erfahrungen damit sammeln und bin immer noch dran.
Es liegt viel an der eigenen Körperschwingung. Ist diese erhöht kann man einige physikalischen Hürden bewältigen auch immun werden gegenüber Eektrosmog und anderem…
Jeder kann seine eigene Körperschwingung erhöhen in dem Stress und unnötige und blockierende Eigenschaften nachhaltig hinter sich gelassen werden.
Wie? Da gibt es viele Möglichkeiten die das Leben ganz individuelle vorgehensweisen anbietet. Was es sicher braucht, ist Mut und sich ab und zu ins nichts zu begeben um, dann wieder wie ein Kind offen für das Neue zu sein.
Interessiert etwas Neues auszuprobieren und ohne Erwartung einfach mal einzutauchen und sich selber zu beobachten, was mit einem geschieht, öffnet viele neue Möglichkeiten. Wie wenn man in ein tolles Theaterstück eintaucht oder einen berührenden Film guckt. Ohne Voreinnahme und einfach magisch wie aus Kinderaugen.
Das Leben ist ein grosser Spielplatz mit vielen Rätzel, löse es auf deine eigene Weise. Der Mensch kann viel mehr als wir in unserer momentanen Gesellschaft gelernt bekommen und geht weit über den Tellerrand hinaus.
Viel Selbstverantwortung, Spass, Geduld, Selbstkritik und Ehrlichkeit auf deiner eigenen ganz persönlichen Entdeckungsreise wünscht
Pascale Kalbermatten
LikeLike